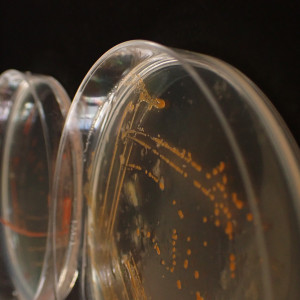
Isolated kelp associated bacteria

Projetos
Projetos
Avançar a ciência, projeto a projeto
O nosso portfolio de investigação inclui mais de 80 projetos em curso e centenas de projetos já concluídos, desenvolvidos em colaboração com centenas de parceiros nacionais e internacionais do mundo académico, indústria, administração pública e sociedade. Todo este trabalho é possível devido a diversas fontes de financiamento, que vão desde iniciativas nacionais ao apoio de prestigiadas agências de financiamento internacionais.